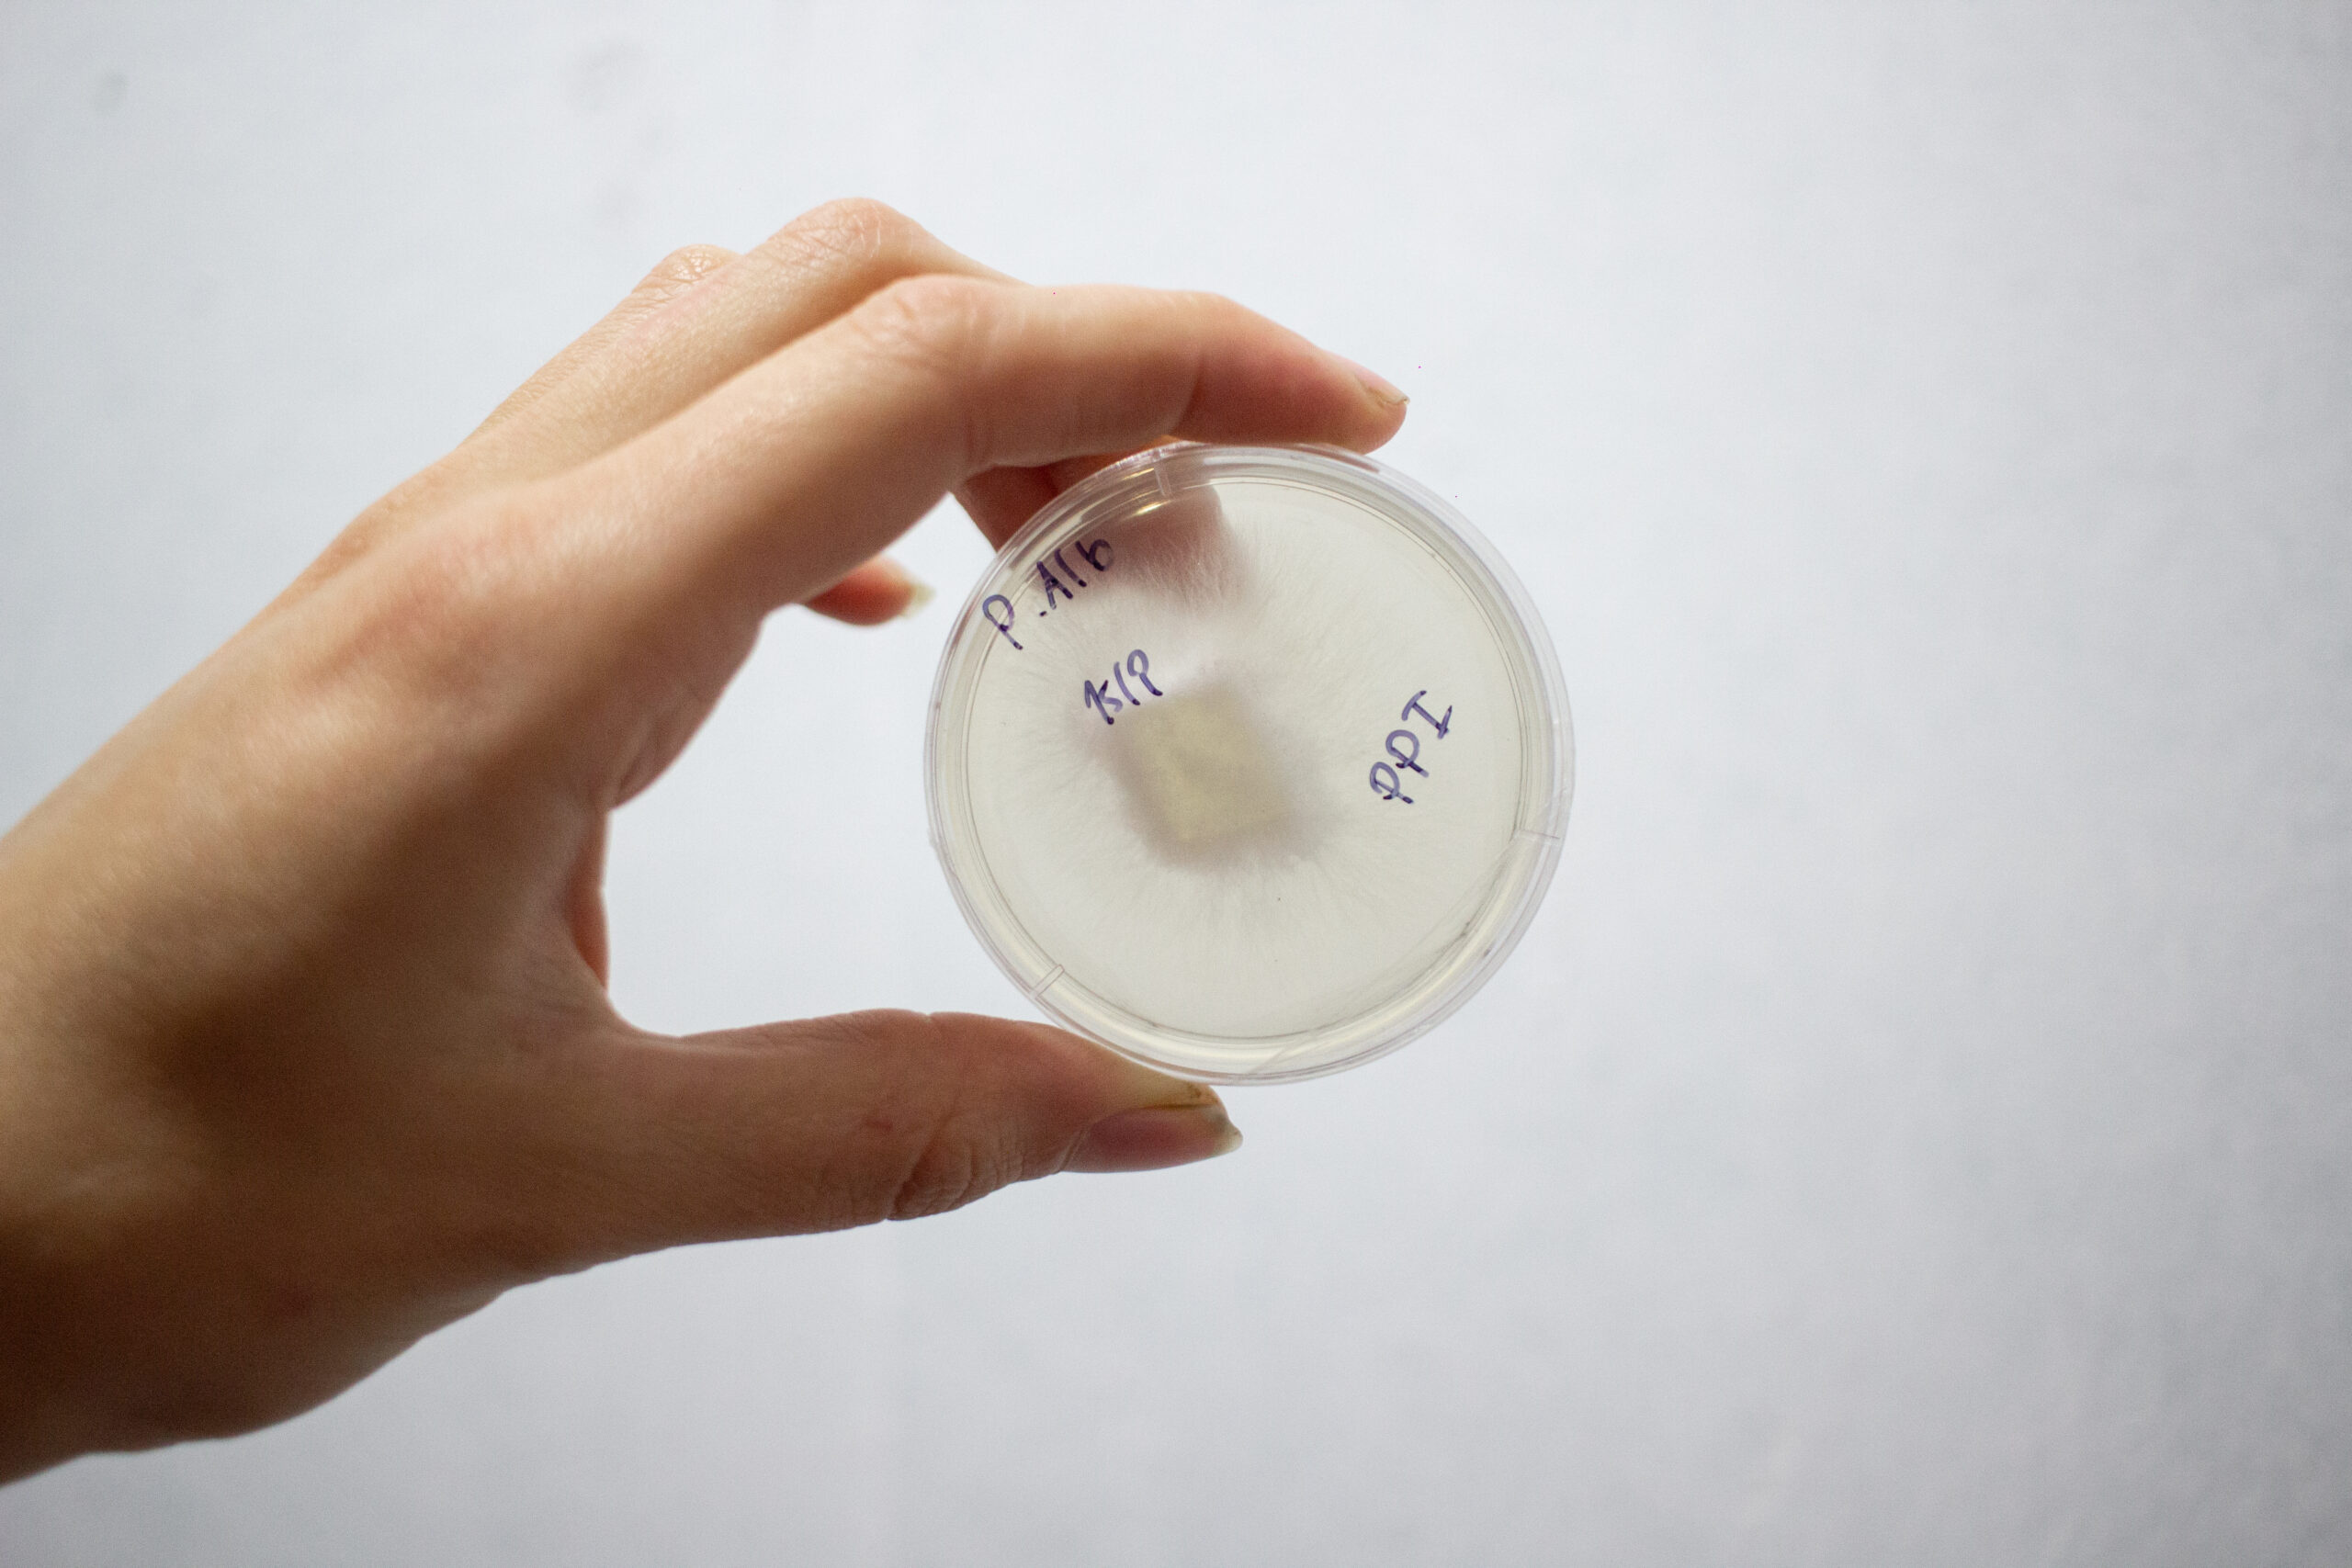
Instalaciones

Fungico AR
Producimos Hongos Gourmet y Adaptógenos

Hongos Frescos | Insumos para el cultivo | Tinturas
Grocery Store
Descubrí una selección de hongos frescos, deshidratados, tinturas y adaptógenos que nutren, equilibran y potencian cuerpo y mente. Calidad, pureza y respeto por la naturaleza en cada producto. Gracias por apoyar este proyecto micelial. Estamos para ayudarte en cada paso.

Nuestros productos
Hongos Frescos | Insumos para el cultivo | Tinturas
Potente y altamente biodisponible, nuestra tintura de Cordyceps es elaborada mediante un proceso de doble extracción (alcohol y agua) para asegurar la máxima concentración de compuestos activos como los beta-glucanos, cordicepina y adenosina. La extracción es asistida por ultrasonido, una tecnología que mejora la ruptura celular del hongo, permitiendo una liberación más eficiente de sus principios activos y optimizando su absorción por el organismo.
Comprar
Nuestra tintura de Reishi (Ganoderma lucidum) es un doble extracto (hidroalcohólico + decocción acuosa) elaborado con una innovadora asistencia por ultrasonido, lo que permite una extracción más profunda y eficiente de los compuestos bioactivos del hongo.
Comprar
Nuestro extracto de Melena de León está elaborado mediante un proceso de doble extracción (alcohol y agua), lo que garantiza una mayor biodisponibilidad de sus compuestos activos, como los hericenonas y erinacinas, conocidos por su potencial para apoyar la salud cognitiva, la memoria y el sistema nervioso.
Comprar

Instalaciones

Instalaciones
Instalaciones

Instalaciones

Instalaciones
FungiBoys
Nuestro equipo

Pancho
Cientifico
Lorem Ipsum is simply dummy text of the printing and typesetting industry. Lorem Ipsum has been the industry's standard dummy text ever since the 1500s, when an unknown printer took a galley of type and scrambled it to make a type specimen book.

Nico
Todoterreno
Lorem Ipsum is simply dummy text of the printing and typesetting industry. Lorem Ipsum has been the industry's standard dummy text ever since the 1500s, when an unknown printer took a galley of type and scrambled it to make a type specimen book.

Juani
Chief
Lorem Ipsum is simply dummy text of the printing and typesetting industry. Lorem Ipsum has been the industry's standard dummy text ever since the 1500s, when an unknown printer took a galley of type and scrambled it to make a type specimen book.







